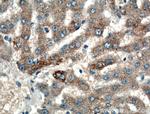
GYS1 Antibody in Immunohistochemistry (Paraffin) (IHC (P))

Search
Proteintech
GYS1 Polyclonal Antibody
{{$productOrderCtrl.translations['antibody.pdp.commerceCard.promotion.promotions']}}
{{$productOrderCtrl.translations['antibody.pdp.commerceCard.promotion.viewpromo']}}
{{$productOrderCtrl.translations['antibody.pdp.commerceCard.promotion.promocode']}}: {{promo.promoCode}} {{promo.promoTitle}} {{promo.promoDescription}}. {{$productOrderCtrl.translations['antibody.pdp.commerceCard.promotion.learnmore']}}
产品信息
10566-1-AP
种属反应
已发表种属
宿主/亚型
分类
类型
抗原
偶联物
形式
浓度
规格
纯化类型
保存液
内含物
保存条件
运输条件
产品详细信息
Immunogen sequence: RAIFATQRQ SFPPVCTHNM LDDSSDPILT TIRRIGLFNS SADRVKVIFH PEFLSSTSPL LPVDYEEFVR GCHLGVFPSY YEPWGYTPAE CTVMGIPSIS TNLSGFGCFM EEHIADPSAY GIYILDRRFR SLDDSCSQLT SFLYSFCQQS RRQRIIQRNR TERLSDLLDW KYLGRYYMSA RHMALSKAFP EHFTYEPNEA DAAQGYRYPR PASVPPSPSL SRHSSPHQSE DEEDPRNGPL EEDGERYDED EEAAKDRRNI RAPEWPRRAS CTSSTSGSKR NSVDTATSSS LSTPSEPLSP TSSLGEERN (430-737 aa encoded by BC007688)
靶标信息
Glycogen Synthase 1 (GYS1) catalyzes the addition of glucose monomers to the growing glycogen molecule through the formation of alpha-1,4-glycoside linkages. Mutations in this gene are associated with muscle glycogen storage disease. Alternatively spliced transcript variants encoding different isoforms have been found for this gene.
仅用于科研。不用于诊断过程。未经明确授权不得转售。
生物信息学
蛋白别名: EC 2.4.1.11; Glycogen [starch] synthase, muscle; glycogen synthase; Glycogen synthase 1; glycogen synthase 1 (muscle); glycogen synthase 3, brain; unnamed protein product
基因别名: GSY; GYS; GYS1; Gys3; MGS
UniProt ID: (Human) P13807, (Rat) A2RRU1, (Mouse) Q9Z1E4
Entrez Gene ID: (Human) 2997, (Rat) 690987, (Mouse) 14936